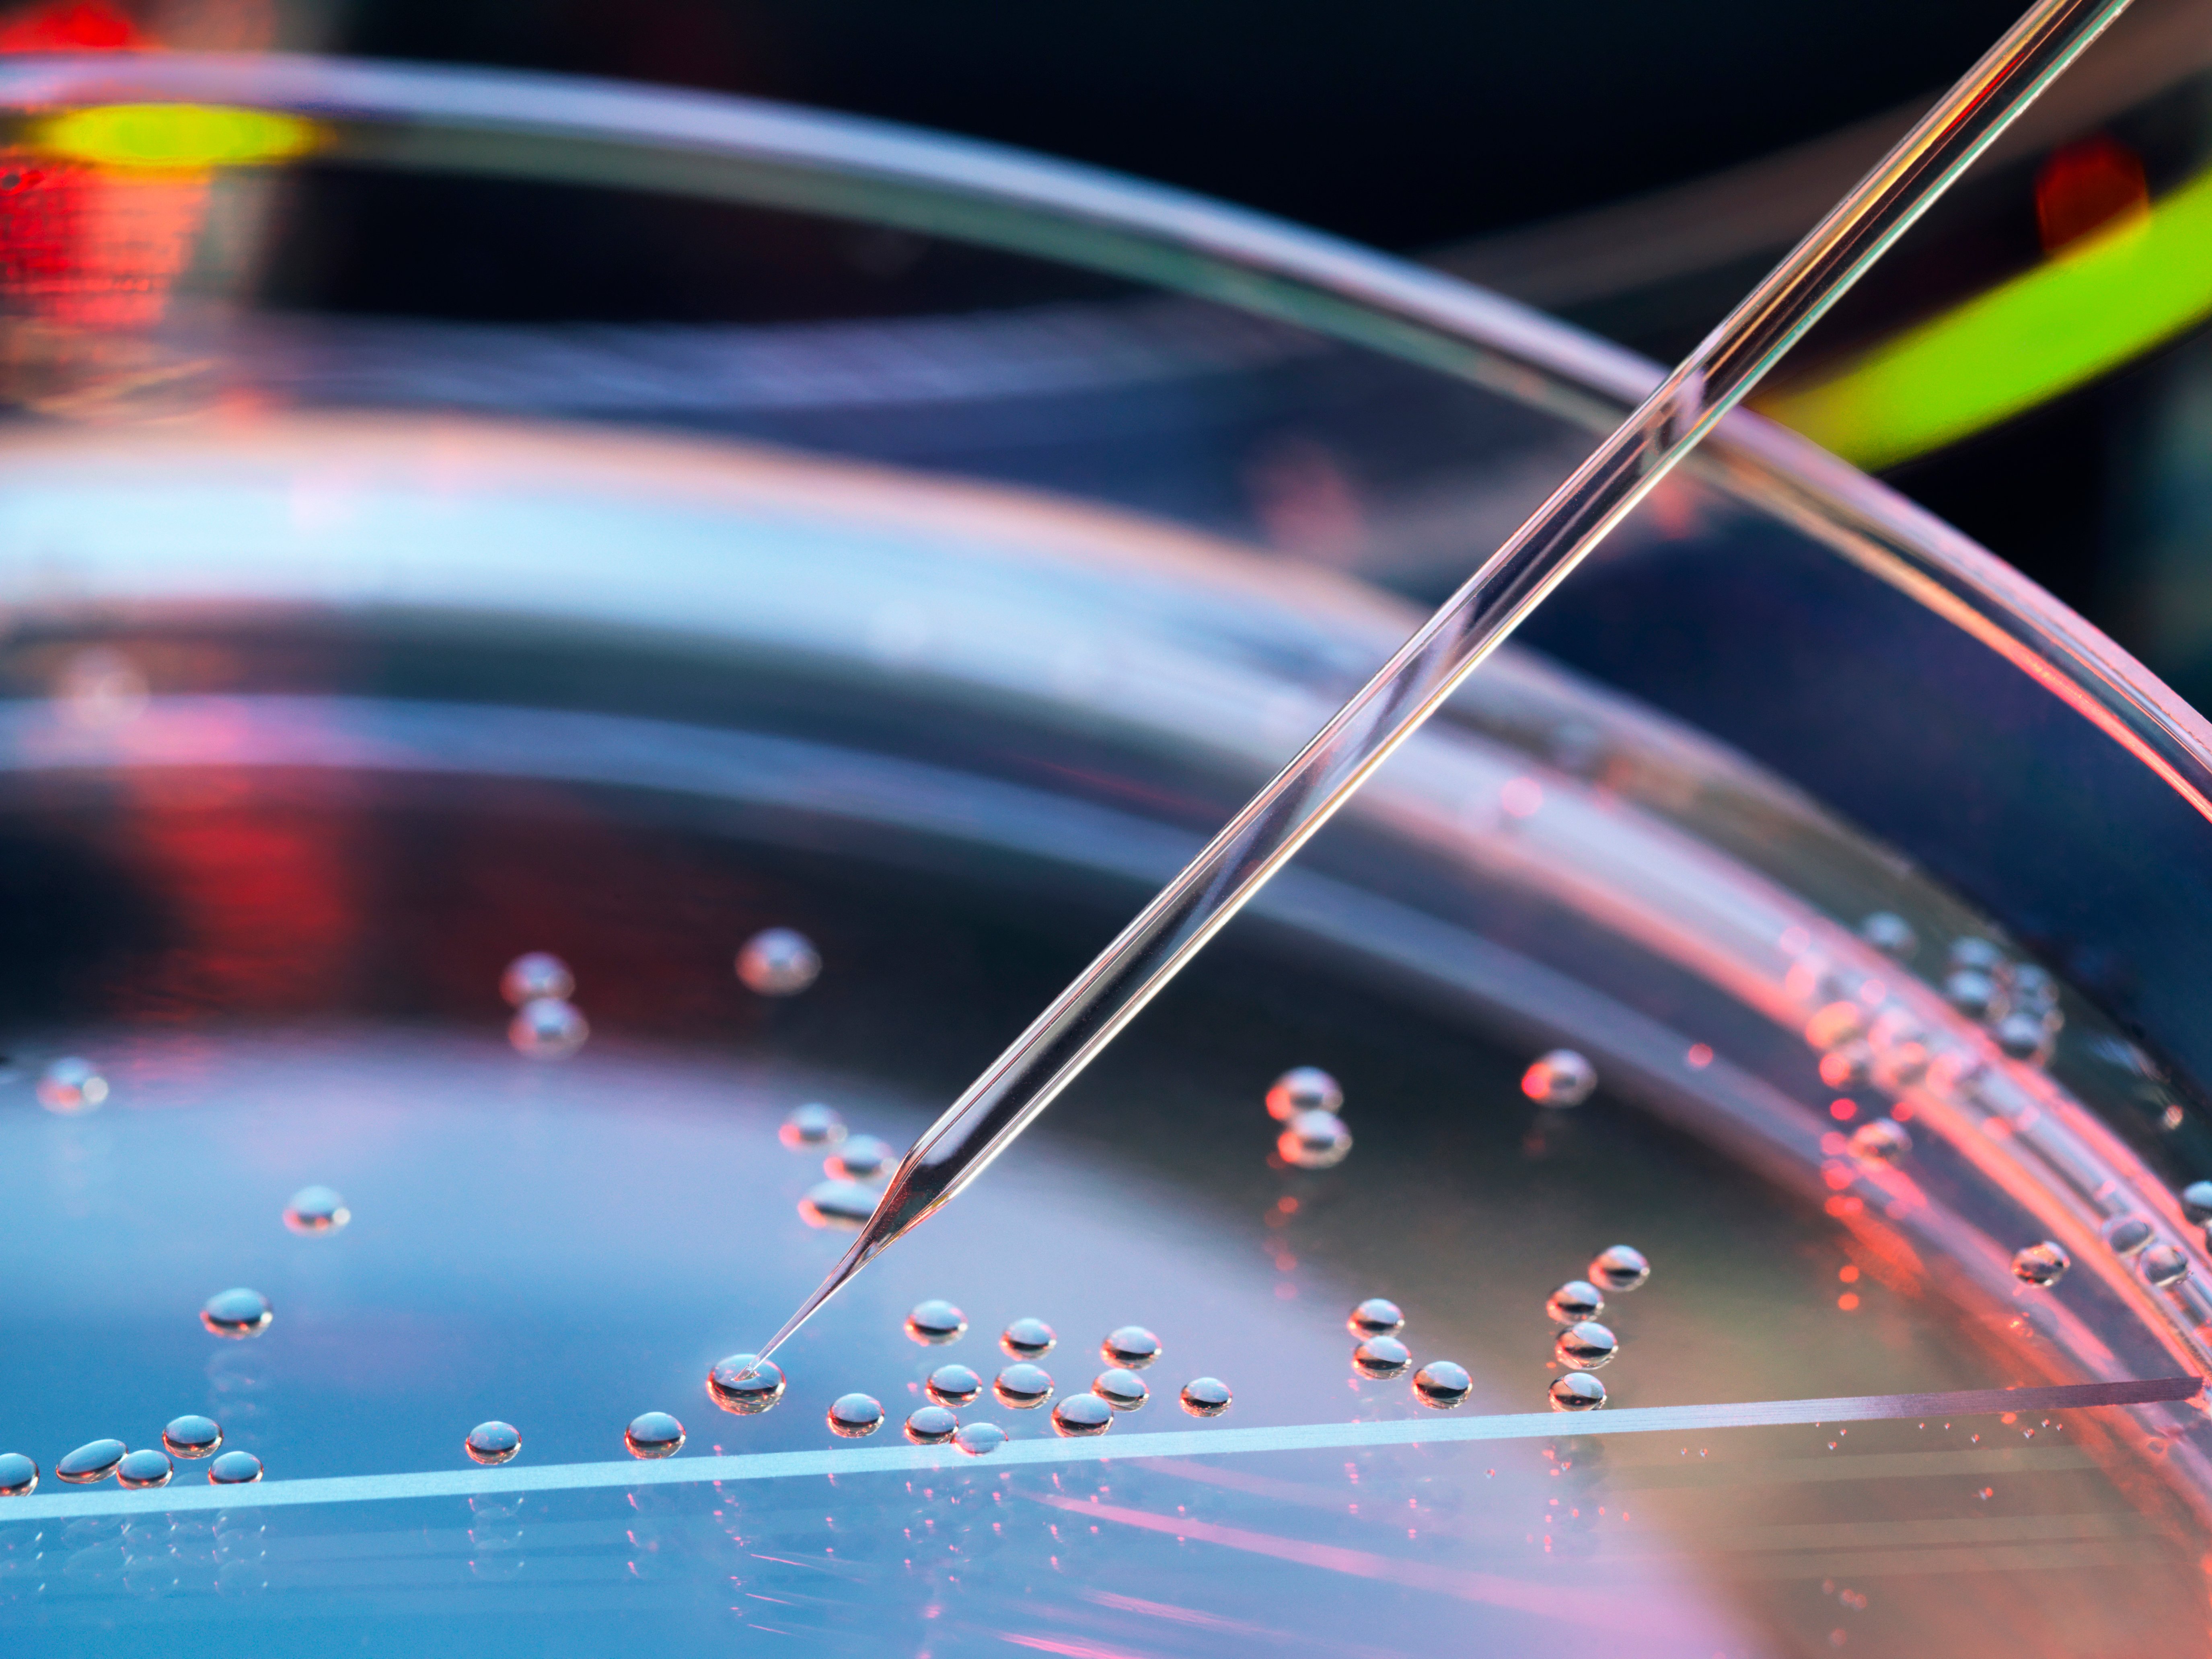
GettyImages-961109594-Dropper_Closeup-RET-1

Solutions
Our solutions help achieve measurable impact and bridge access to life-saving therapies for patients
Health care business leaders today face rising pressure to deliver measurable impact—faster, smarter, and with greater confidence.
From commercialization strategy and planning to our cutting-edge product offerings, to effective communications with decision makers across market access, provider, patient, and corporate audiences, we deliver integrated solutions that drive engagement, differentiation, and commercial success. All to help achieve measurable impact and bridge access to life-saving therapies for patients.

Your Full-Spectrum Partner for Strategy, Innovation, and Impact.
Discover how our end-to-end expertise and unique approach can ensure your treatments make a lasting impact.